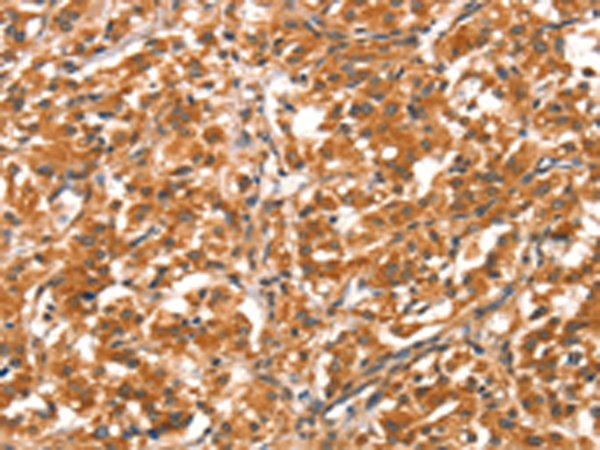

别名:AIP1; AIP-1; AF9Q34; DIP1/2应用:IHC
反应种属:Human, Mouse, Rat
规格:50μl/100μl
| Description |
|---|
| DAB2IP is a Ras (MIM 190020) GTPase-activating protein (GAP) that acts as a tumor suppressor. The DAB2IP gene is inactivated by methylation in prostate and breast cancers |
| Specification | |
|---|---|
| Aliases | AIP1; AIP-1; AF9Q34; DIP1/2 |
| Swissprot | Q5VWQ8 |
| Host/Isotype | Rabbit IgG |
| Storage | Store at 4°C short term. Aliquot and store at -20°C long term. Avoid freeze/thaw cycles. |
| Species Reactivity | Human, Mouse, Rat |
| Immunogen | Synthetic peptide of human DAB2IP |
| Formulation | pH7.4 PBS, 0.05% NaN3, 40% Glycerol |
| Application | |
|---|---|
| IHC | 1/50-1/200 |
| ELISA | 1/2000-1/5000 |
 |
The image is immunohistochemistry of paraffin-embedded Human gasrtic cancer tissue using P04814(DAB2IP Antibody) at dilution 1/40. (Original magnification: ×200) |
|
The image is immunohistochemistry of paraffin-embedded Human thyroid cancer tissue using P04814(DAB2IP Antibody) at dilution 1/40. (Original magnification: ×200) |
本公司的所有产品仅用于科学研究或者工业应用等非医疗目的,不可用于人类或动物的临床诊断或治疗,非药用,非食用。
暂无评论
本公司的所有产品仅用于科学研究或者工业应用等非医疗目的,不可用于人类或动物的临床诊断或治疗,非药用,非食用。
 中文
中文 








发表回复